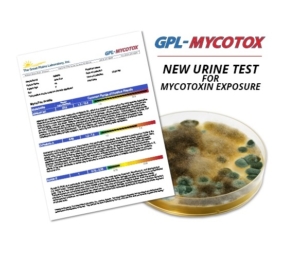

Integrative Healthcare Symposium 2018 New Product Showcase
By Katherine Shagoury
Find the latest clinically-relevant products and services to enhance your practice and keep your patients in touch with the latest in integrative healthcare.
Click here for more information.
Bioceuticals—Biofloractive 500 Us
Company Info
Product Description
BioFloractiv 500
Super Strength, 14 Strain Probiotic
BioFloractiv 500 is a combination of 14 probiotic strains providing 500 billion CFU per 5g sachet. This high strength probiotic provides support for normal healthy digestive and immune systems in a convenient one-a-day dose. It provides good bacteria which may help maintain intestinal flora when taken during and after antibiotic therapy.
Features:
- High strength, intensive probiotic.
- 14 probiotic strains providing 500 billion CFU.
- Convenient one-a-day dose.
- May help to maintain intestinal microbiota when taken during and after antibiotic therapy.
- Aids digestion and supports digestive health.
- Supports a normal healthy immune system.
- Halal and Kosher certified.
Contact: Felicity Nevin
Email: [email protected]
Bioron—Coldcalm Liquid Dose
Company Info
Product Description
ColdCalm Liquid Doses temporarily relieves sneezing, runny nose, and nasal congestion for children age 6 months and up. The sterile, single-use doses eliminate the need for preservatives and helps prevent contamination. ColdCalm Liquid Doses does not contain alcohol, flavors, dyes, lactose, sugar, or artificial sweeteners. ColdCalm Liquid Doses has no known drug interactions and is non-drowsy.
Contact: Dana Chadwick
Email: [email protected]
Empirical Labs—Liposomal Multivitamin
Product Description
Liposomal Multivitamin combines 23 ingredients in liposomal form to produce optimal bioavailability.
Contact: Shawn Khan
Email: [email protected]
Metagenics—Ketogenic Formulas
Company Info
Product Description
Introducing an Innovative Practitioner-Grade Line of Ketogenic Formulas
Meeting the requirements of a ketogenic lifestyle can be challenging. These nutritional formulas from Metagenics are designed to provide quick and convenient ways to support patients in reaching their ketogenic program goals.
- Delicious Ketogenic Soup in Savory Chicken flavor
- Tasty Ketogenic Shakes in Chocolate and Vanilla
- MCT Oil & MCT Powder
- Exogenous Ketone Salts
On-Site Contact: Saleem Day
Email: [email protected]
Re-live Everyday—Re-assure Gummies
Company Info
Product Description
Hemp extract gummies that allow for a natural and tasty method of hemp extract supplementation. Featuring no THC and approximately 10mg of hemp extract per gummy, you can be Re-Assured you are Reliving your best days, every day.
Contact: Amanda Wilters
Email: [email protected]
Standard Process—Calamari Omega Liquid
Company Info
Product Description
Calamari Omega-3 Liquid is a convenient, sustainable way to increase omega-3 essential fatty acid intake for targeted system support, as well as overall well-being.*
*This statement has not been evaluated by the Food & Drug Administration. This product is not intended to diagnose, treat, cure or prevent any disease.
Contact: Jenna Schaefer
Email: [email protected]
Standard Process—Tuna Omega Oil
Delivers essential omega-3 fatty acids. Supports normal lipid profiles within normal range, cognition, skin and hair health, emotional balance and the body’s natural inflammatory response function as it relates to periodic challenges like consumption of high-fat meal or strenuous activity.
Contact: Jenna Schaefer
Email: [email protected]
Standard Process—Veg-e Complete Protm Vanilla
Company Info
Product Description
Veg-E Complete Pro Vanilla offers an organic multisource blend of plant-based protein in an convenient powder with delicious vanilla flavor.
The blend of organic pea protein, organic pumpkin seed protein, and organic sesame seed protein provides a complementary combination of amino acids that supplies all nine essential amino acids in the recommended amounts for a complete amino acid profile7. Veg-E Complete Pro provides 15 grams of vegan protein in a convenient, great-tasting shake.*
Contact: Jenna Schaefer
Email: [email protected]
Standard Process—Mediherb® Turmeric Forte
Company Info
Product Description
NEW MediHerb® Turmeric Forte, with standardized bioavailable curcumin, supports a healthy inflammation response.*
This curcumin and fenugreek fiber formulation demonstrated enhanced curcuminoids bioavailability than unformulated curcumin.1
- Kumar D et al. Journal of Functional Foods. 2016; 22, 578-587
*This statement has not been evaluated by the Food & Drug Administration. This product is not intended to diagnose, treat, cure or prevent any disease.
Contact: Jenna Schaefer
Email: [email protected]
Standard Process—Veg-e Complete Protm Chocolate
Veg-E Complete Pro Chocolate offers an organic multisource blend of plant-based protein in an convenient powder with delicious chocolate flavor.
The blend of organic pea protein, organic pumpkin seed protein, and organic sesame seed protein provides a complementary combination of amino acids that supplies all nine essential amino acids in the recommended amounts for a complete amino acid profile7. Veg-E Complete Pro provides 15 grams of vegan protein in a convenient, great-tasting shake.*
Contact: Jenna Schaefer
Email: [email protected]
The Great Plains Laboratory, Inc.—Gpl-mycotox Profile
Company Info
Product Description
The GPL-MycoTOX screens for seven different mycotoxins from four species of mold, in one urine sample. We use advanced mass spectrometry (MS/MS) to detect lower levels of mold toxicity at the most sensitive rate available. Symptoms linked to mycotoxin exposure include Lyme disease, heart disease, asthma, sinusitis, cancer, memory loss, vision loss, chronic fatigue, skin rashes, depression and liver damage.
Contact: Kelsey Wittman
Email: [email protected]